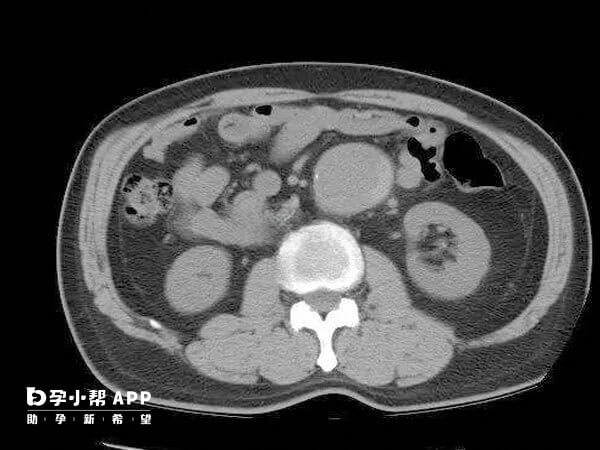
经腹的手术过程较复杂

腹腔镜子宫切除手术是一种微创手术,具有创伤小、恢复快等优点。一般患者手术前会进行常规检查,随后就可以进行麻醉了,当全身麻醉生效后,消毒腹部并在脐部做小切口,此时医生就会进行腹腔镜子宫切除手术操作了,一般整个流程并不复杂,患者做完手术之后,注意多休息就可以了。

切除子宫通常情况下是由于子宫患病,需要做子宫切除手术的疾病包括子宫内膜的疾病,子宫肌瘤或者是子宫腺肌症,功能性子宫出血,经保守治疗效果不好,需要做手术治疗。

子宫切除手术通常有3种途径,经腹子宫切除,经腹腔镜子宫切除以及经阴道子宫切除。临床上常根据子宫的大小,活动度,盆腔有无粘连等实际情况来选择做哪项手术。
子宫切除手术按照其做法可以分为三种手术方式:
一种手术方式经腹的手术,也就是是传统的开腹手术,在腹部起止之间取于中形切口来做子宫切除手术;
还有一种就是经阴道的手术,根据疾病类别以及子宫的大小选择应是子宫切除术;
另外一种就是腹腔镜下的手术,目前临床上广为推广的腹腔镜下的子宫切除手术。
我们都知道子宫切除手术的类型包括经腹的手术、经阴道的手术和腹腔镜下的手术三种,三种手术的操作步骤是不同的。详情如下:
一、经腹的手术过程
1、取仰卧位,腹部皮肤消毒,铺巾,逐步切开腹壁进入腹腔。
2、探查盆腔、腹腔,全面探查盆腔及腹腔各脏器。
3、用两把长弯钳,沿宫角钳夹子宫两侧,提起子宫及双侧附件。
4、分别处理两侧圆韧带,分别处理两侧附件。
5、剪开膀胱子宫,反折腹膜,下推膀胱,处理子宫动、静脉。
6、分别处理子宫骶骨韧带及主韧带。
7、切除子宫,缝合阴道残端;检查各残端是否出血,缝合皮肤。
二、腹腔镜下的手术过程
1、手术前常规消毒后进行硬膜外麻醉或全麻。
2、患者采取膀胱截石位,然后常规消毒,镀金,盖单。
3、从下腹部充气,穿刺套管然后放置腹腔镜。
4、利用腹腔镜探查盆腔以了解子宫大小形态和位置与周围脏器关系。
5、向子宫内上方用钳夹提起子宫角的圆韧带,用剪刀剪断圆韧带。同样方法处理对侧圆韧带。
6、剪开子宫膀胱反折腹膜以及两侧圆韧带前叶,将膀胱向下推,将圆韧带前叶外缘向外下方稍微分离。
7、提起一侧输卵管用双极电凝钳充分电凝韧带,使韧带内血管闭合,在其中部小心剪断,附件就切除了。
8、继续分离膀胱反折腹膜,将膀胱下推,电凝分离宫颈膜和两侧的膀胱柱,然后将膀胱推到宫颈外口。
9、切断子宫动脉,这是最关键的一步,一不小心就会引起出血,医生会加倍小心处理。
10、用双极电凝钳剪断子宫骶骨韧带以及大部分子宫主要韧带,然后切开阴道前穹窿,切除子宫。
11、切除的子宫可以经过阴道取出,在腹腔镜下缝合阴道残端和反折腹膜。
12、冲洗腹部盆腔,吸净积液,排出气体后取出宫腔镜以及套管,缝合各个穿刺孔。
切除子宫具体的手术时间还要根据手术方法而定,如果做腹腔镜子宫切除的话是全麻,如果是做开腹子宫切除的话就是半麻。目前临床上多采用的是腹腔镜微创技术,这种方法对于全子宫切除损伤比较小,而且患者恢复的时间也比较快,整个的手术过程大约需要两个小时左右,患者第2天就可以下床走路。

患者病情不同也会影响到子宫切除手术的时间,病情严重的患者需要的时间会比较长,病情较轻的患者需要的时间比较短,子宫切除手术时间受到多种因素的影响,具体时间需要根据患者自身病情来确定。
文章更新时间:2025-08-1817:26:01
位姐妹
高龄/绝经试管
助孕攻略群
位姐妹
不孕不育
助孕经验群
位姐妹
染色体异常
备孕交流群
位姐妹
三代/四代试管
助孕交流群